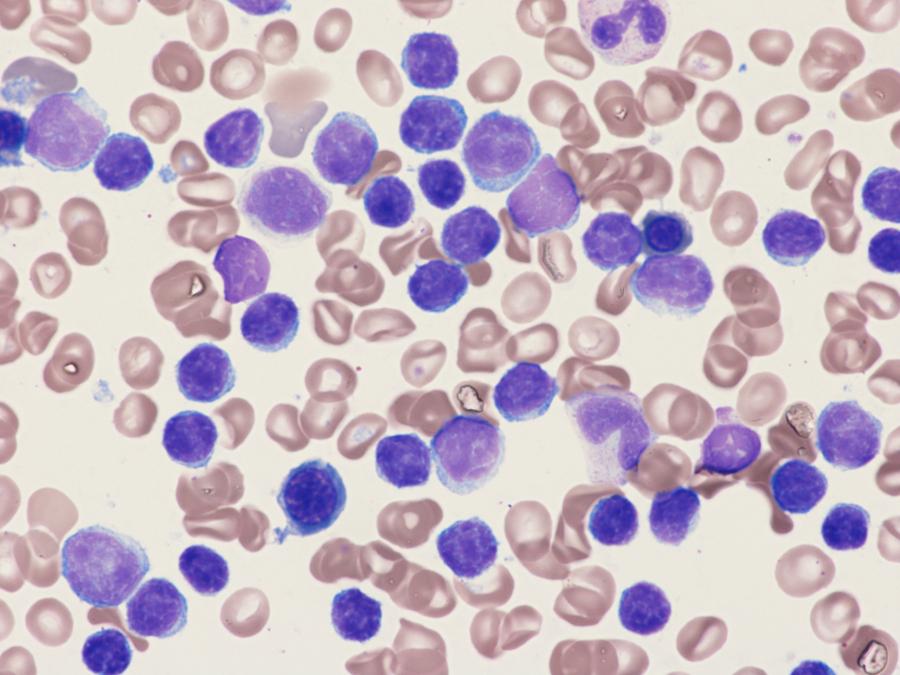

花蓮慈濟醫院黃威翰醫師表示,慢性淋巴性白血病疾病若惡性度較高,則進展快,患者常見出現的症狀,包括夜間盜汗、莫名發燒、體重莫名減輕、疲憊、淋巴結腫大、貧血等。

曾有一名83歲的陳爺爺,解尿困難多時,至醫院看診發現有尿路結石問題,術前進行多項相關檢查時,醫師意外發現,他的白血球數量異常,且肝脾有些微腫大的現象,轉診至血液腫瘤科進一步檢查後,才確診為慢性淋巴性白血病(Chronic Lymphocytic Leukemia,簡稱CLL)。
慢性淋巴性白血病 有症狀才需治療
「病患確診前幾乎沒有相關症狀,這也是多數慢性淋巴性白血病患者的普遍情形。」收治案例的花蓮慈濟醫院幹細胞與精準醫療研發中心免疫治療科副主任黃威翰醫師表示,慢性淋巴性白血病是一種進展緩慢的疾病,台灣每年新增約150至200人,患者體內會有淋巴球不正常增生的現象,若無症狀,病人只需定期追蹤。在新發病的患者當中,只有一至兩成病人,具有症狀或疾病進展快速,才需要開始接受治療。

慢性淋巴性白血病分為0至4期,0期患者血中淋巴球數量較高,但無疾病相關症狀,進展緩慢;第1期除了血中淋巴球增生外,淋巴腺亦比正常稍微腫大;第2期,血中淋巴球增加、有肝脾腫大現象,淋巴腺可能較正常腫大;第3期,除了血中淋巴球數量增加,伴隨貧血,淋巴腺、肝臟、脾臟都比正常腫大;第4期,除第3期症狀外,還有血小板低下問題。
慢性淋巴性白血病會有白血球數量異常問題。
惡性度影響治療決策 症狀出現是關鍵
「不只疾病分期,確認惡性度高低也是評估治療重要的一環。」黃醫師分享,慢性淋巴性白血病疾病若惡性度較高,則進展快,患者常見出現的症狀,包括夜間盜汗、莫名發燒、體重莫名減輕、疲倦、淋巴結腫大、貧血等,因此病人在追蹤期間若出現相關症狀,則需審慎評估並接受治療。

若懷疑有慢性淋巴性白血病問題,應及早就醫。
化療+單株標靶藥至多2年 經濟負擔成接續治療考量
黃醫師指出,慢性淋巴性白血病的藥物治療可以依照疾病的嚴重度使用一線口服化療,或是使用單株抗體標靶藥物搭配化學治療,端視病人耐受狀況與本身共病等因素,來選擇前幾線最理想的治療組合。
使用單株抗體標靶藥物及化學治療後,針對高危險的病患族群,目前有兩類不同機制的口服標靶藥物可以選擇,且因為口服的方便性能為病人帶來更好的治療生活品質,然而治療藥物費用價格不便宜。

如今臨床上CD20單株抗體標靶藥,除了原廠藥外,近來也有生物相似藥能選擇。生物相似藥價格較爲低廉,亦能提供與原廠藥相仿的治療效果,上市前需要經過短期的臨床試驗,證實其安全性與療效與與原廠藥一致,才能核准上市,以藥品成本與治療效力交叉考量下,能帶來良好的療效外,也降低醫療門檻,在歐美國家備受推崇。
慢性淋巴性白血病有別於一般癌症,只要病人早期發現治療,就像是三高等慢性疾病的存在,初期及中期配合治療,平均存活時間至少約7年以上,提醒民眾毋須害怕,若懷疑有相關問題應及早就醫,與醫師共同討論決定最理想的治療方式。

【本文獲「健康醫療網」授權轉載。】
















